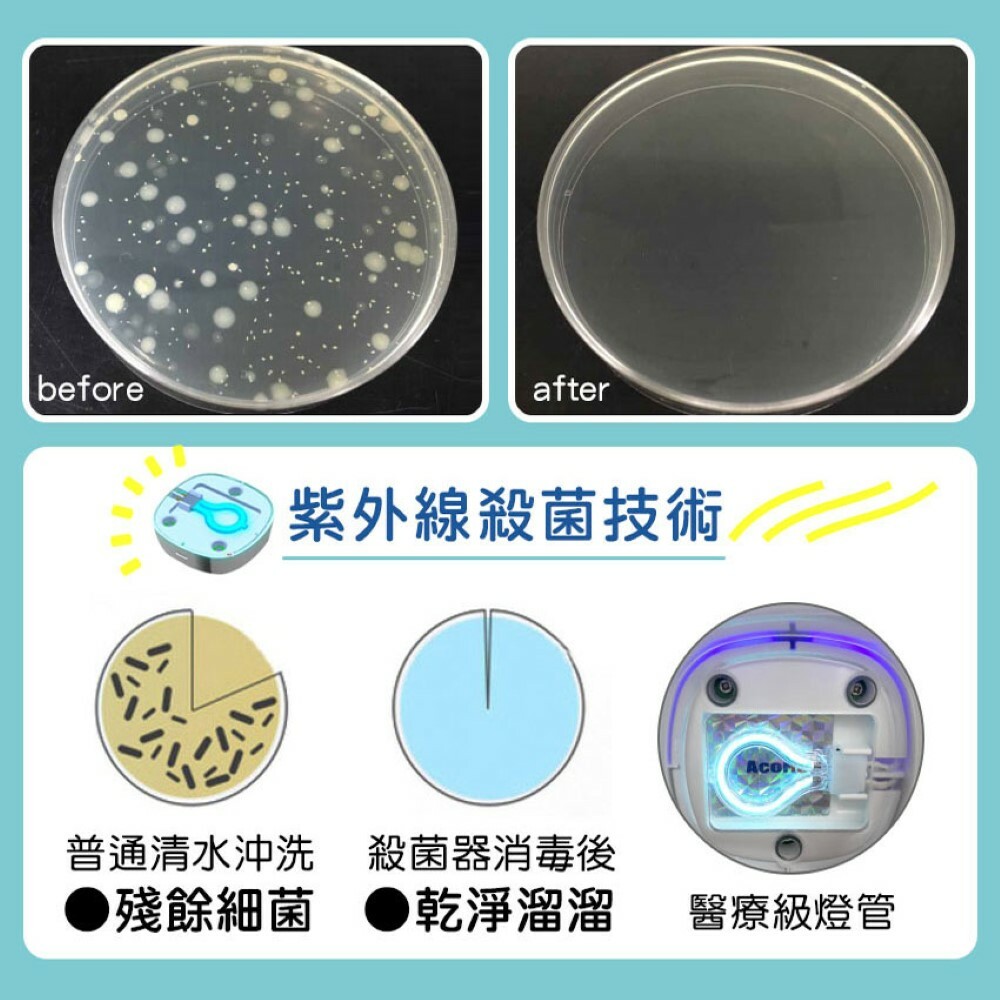

{{ 'fb_in_app_browser_popup.desc' | translate }} {{ 'fb_in_app_browser_popup.copy_link' | translate }}
{{ 'in_app_browser_popup.desc' | translate }}
質感商品 • 溫暖服務 • 品味生活
{{ childProduct.title_translations | translateModel }}
{{ getChildVariationShorthand(childProduct.child_variation) }}
{{ getSelectedItemDetail(selectedChildProduct, item).childProductName }} x {{ selectedChildProduct.quantity || 1 }}
{{ getSelectedItemDetail(selectedChildProduct, item).childVariationName }}
✔紫外線+臭氧,短時間有效殺菌消毒
✔適用各種奶嘴及小型個人衛生用品
✔醫療級UVC燈管,不易斷,更省電
✔兩分鐘智能斷電,電池/USB兩種供電
商品存貨不足,未能加入購物車
您所填寫的商品數量超過庫存
{{'products.quick_cart.out_of_number_hint'| translate}}
{{'product.preorder_limit.hint'| translate}}
每筆訂單限購 -1 件
{{'products.quick_cart.quantity_of_stock_hint'| translate : {message: quantityOfStock} }}

【商品規格】
產地 台灣
材質 PC / 矽膠
尺寸 10.5x5.5x5.5cm
重量 100g
產品內容物 紫外線消毒器x1、底座x1、Micro USB電源線x1
商品重量 100g
安全聲明 皆可使用AAA電池x2 / USB供電 兩種模式
原廠保固:1年
紫外線燈管約可使用6000小時
【注意事項】
●殺菌燈未熄滅時,請勿取出固定底座
●請勿於未安裝固定底座時打開電源
●請勿直視正在進行殺菌的紫外線燈管
●主機請勿清洗
●主機請勿重摔
●請勿在無大人陪同時讓小孩使用
●建議使用鹼性電池或充電電池